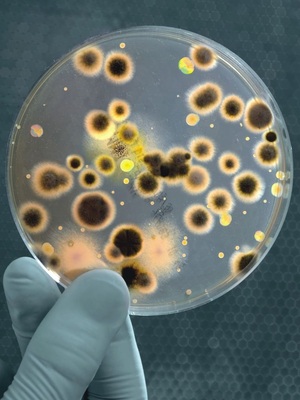
Im Trinkwasser enthaltene Mikroorganismen sind weitaus häufiger für Infektionen verantwortlich, als bisher vermutet.

Die in Deutschland seit Mai 2001 gültige Trinkwasserverordnung (TrinkwV) definiert klar die Verantwortungsbereiche beim Umgang mit dem Lebensmittel Trinkwasser. Konkret lautet eine der wesentlichen Forderungen: Die Trinkwasserqualität muss bis zum Austritt an der Zapfstelle eingehalten werden. Das gilt in Gebäuden für Wasser, das zum Trinken, zur Zubereitung von Speisen und Getränken (Küche) sowie zur Körperpflege und -reinigung (Dusche, Bad) zum Einsatz kommt. Das Wasser muss frei von Krankheitserregern, genusstauglich und rein sein. Diese Forderungen gelten als erfüllt, wenn bei der Wassergewinnung, der Wasseraufbereitung und auch bei der Verteilung (Hausinstallation) die allgemein anerkannten Regeln der Technik eingehalten werden. Nach den Vorkommnissen in Ulm (5 Tote und 64 Infektionsfälle) sollten Betreiber ihre generelle Organisationshaftung ernster nehmen.
Keime sind eine permanente Gefahr in der Hausinstallation
Hygienische Gesichtspunkte spielen dabei eine wesentliche Rolle. Die VDI 6023 definiert unter Hygiene die Gesamtheit aller Bestrebungen und Maßnahmen zur Verhütung von mittelbaren oder unmittelbaren gesundheitlichen Beeinträchtigungen und Störung des Wohlbefindens bei einzelnen Verbrauchern.
Da Wasser, Temperatur und Zeit (hier wird vor allem ein nicht bestimmungsgemäßer Betrieb, gemäß DIN 1988 Teil 8, und das Stagnationsproblem angesprochen) wesentliche Keimwachstumsfaktoren sind, muss jedem Verantwortlichen bewusst sein, dass Trinkwasseranlagen Risiken für die Gesundheit von Verbrauchern darstellen können. Für Betreiber von Trinkwasseranlagen kann eine vernachlässigte (krankheitsverursachende) Hygiene sogar juristische Folgen haben. Im Bundesgesetzblatt Nr. 33 wird im § 7 die Meldepflicht von Krankheitserregern gesetzlich geregelt. Gemäß Absatz (1) ist auch die Legionella zu melden, wenn Nachweise auf eine Infektion hinweisen.
Legionellen – unsere altbekannten Gefährten
Legionellen sind übrigens schon immer Begleiter des Menschen, sie lassen sich in fast allen aquatischen Süßwasserbiotopen nachweisen; sogar aus Thermalquellen konnten sie isoliert werden. Zur Gefahr werden Legionellen in den Warmwasserleitungen der Hausinstallation. Denn Legionellen vermehren sich besonders in erwärmtem Wasser zwischen 30 und 45°C. Begünstigt wird ihr Wachstum durch mangelhaften Wasseraustausch, wenn also das Wasser in Leitungen stagniert, die nur selten benutzt werden. Legionellen finden sich auch in Belägen an den Wänden von Wasserleitungen oder anderen Oberflächen (Biofilme). Wenn Menschen feinstverteilte Tröpfchen einatmen, die Legionellen enthalten, kann dies das Pontiac-Fieber auslösen. Dieses verläuft ähnlich wie eine Grippe. In manchen Fällen kann es zur Legionärskrankheit kommen, einer schweren Lungenentzündung, die ohne Behandlung tödlich sein kann.
In großen und weit verzweigten Wasserverteilungsanlagen ist das Risiko einer Legionellenbesiedlung höher als im Einfamilienhaus, da sich dort vermehrt wenig durchströmte Nischen finden, in denen sich Legionellen festsetzen und vermehren können. Daher treten Probleme mit Legionellen insbesondere in großen Gebäuden wie Krankenhäusern, Hotels, Schwimmbädern, Mehrfamilienhäusern, Industrieanlagen oder Verwaltungsgebäuden auf.
Eine Legionellengefahr besteht auch im warmen Beckenwasser von Schwimmbädern, insbesondere wenn Einbauten in den Becken (Stichwort Spaßbäder) die Bildung von Aerosolen begünstigen. Hinzuweisen ist auch auf eine besondere Gefährdung durch Legionellen in Whirlpools, da hier neben dem besonders warmen Beckenwasser zusätzlich die Durchströmung mit Luft und dadurch eine Aerosolbildung hinzukommt.
Maßnahmen gegen unkontrolliertes Legionellenwachstum
Zunächst sollte man sich vor Augen führen, unter welchen Bedingungen sich Legionellen besonders rasch vermehren (dass sie am schnellsten bei Temperaturen zwischen 30 und 45°C wachsen, wurde bereits beschrieben):
Legionellen bevorzugen Ablagerungen in Trinkwasser-Erwärmern, Rohrleitungen und Armaturen, also sedimentierte anorganische Wasserbestandteile (Kalk!), die große Oberflächen besitzen und gut besiedelt werden können. Auch die Korrosion führt zu solchen Bedingungen. Deshalb gilt: Kalkablagerungen und korrodierte Oberflächen in Rohrleitungen sollten durch eine geeignete Wasseraufbereitung verhindert werden. Dazu sind physikalisch-alternative Geräte zur Verhinderung von Steinbildung in Rohrleitungen und Warmwasserbereitern, aber auch chemisch wirksame Ionenaustauscher und Dosieranlagen geeignet.
Materialien wie Gummi oder Silikon (in Dichtungen, Membranausdehnungsgefäßen, Duschschläuchen, etc.) werden schnell von Mikroorganismen in Form eines Biofilms besiedelt. Aber auch in stagnierendem Wasser in Leitungsteilen mit mangelhafter oder ganz fehlender Zirkulation (tote Leitungsstränge) vermehren sich Legionellen bis zu hohen Konzentrationen.
Betrachtet man sich den Mikrokosmos, also das Lebensumfeld dieser Bakterien, so wird sicherlich vieles leichter verständlich: Legionellen haben in der Regel einen Durchmesser von 0,3–0,9 μm und sind ca. 0,5–5 μm lang. Für diese meist stäbchenförmigen kleinen Lebewesen stellt eine Kalkinkrustation von 1–10 mm (das ist bei alten verzinkten Systemen keine Besonderheit) ein Gebirge im Ausmaß der Alpen im Vergleich zum Menschen dar. Die Maßeinheit für die Konzentration an Legionellen im Wasser ist KBE (kolonienbildende Einheit). So sagt der Wert 100 KBE/100 ml (hohe Kontamination) aus, dass sich 100 x 10 x 1000 = eine Million Legionellen pro m³ Wasser im System befinden!
Auch die Vermehrung, die gleichgeschlechtlich durch Teilung geschieht, ist für das Verständnis der Problematik wichtig. Legionellen verdoppeln sich in Trinkwasseranlagen bei Temperaturen um 30–40 °C alle 22 bis 72 h, d. h. bei einer konservativen Annahme von einer Verdoppelungszeit von drei Tagen würde eine Kontamination mit 1000 KBE (z. B. eine mit Legionellen befallene Amöbe) nach drei Tagen 2000 und nach 30 Tagen eine Million KBE bedeuten.
Doch es gibt Maßnahmen, um das Legionellen-Problem in den Griff zu bekommen. Das Umweltbundesamt gibt beispielsweise folgende Empfehlungen zum sicheren Bau und Betrieb von Warmwasserverteilungsanlagen und Bädern:
- Neue Wasserverteilungsanlagen müssen so geplant, gebaut und betrieben werden, dass eine Besiedlung mit Legionellen nicht zu befürchten ist. Dazu hat der Deutsche Verband für das Gas- und Wasserfach (DVGW) ein Arbeitsblatt W 551 herausgegeben.
- Alle Wasserverteilungsanlagen müssen regelmäßig untersucht werden. Das Arbeitsblatt beschreibt die mikrobiologische Überwachung der Anlagen und gibt Hinweise für eine möglicherweise notwendige Sanierung.
- Für den Betrieb von Schwimmbädern gilt die DIN 19643. Neben anderen Anforderungen an die Wasserqualität in Schwimm- und Badebecken enthält diese Norm auch die Vorgabe, dass Legionellen im Badebeckenwasser wie auch im Filtrat nicht nachweisbar sein dürfen.
- Anlagen, bei denen eine Verkeimung bekannt ist, können durch Sanierungsmaßnahmen wieder sicher werden.
Sanierung und Betrieb gemäß W 552
Generell kann man drei Sanierungsmethoden, die auch in Kombination angewendet werden können, unterscheiden: (a) die technische Sanierung; (b) die thermische Desinfektion; (c) die chemische Desinfektion. Wesentlich für eine erfolgreiche Sanierung ist zunächst die Dokumentation des vorhandenen Systems (Kalt- und Warmwasser). Erfasst werden müssen:
- das System der Warmwassererzeugung und der Warmwasserspeicherung
- Leitungsverlauf, Nennweiten und Werkstoffe, Armaturen, Dämmstoffe und deren Dicke
- Anschluss von Geräten und Einrichtungsgegenständen sowie Regel- und Steuerungseinrichtungen
- Anlagendaten (Wasserverbrauch, Temperaturen, usw.).
Auf Basis dieser Dokumentation sind anschließend die planerischen Maßnahmen festzulegen, die zu einer Verminderung der Kontamination mit Legionellen führen. Anlagenteile, in denen eine Sedimentation bzw. Inkrustation stattgefunden haben kann (z. B. Trinkwassererwärmer, Verteiler) sind vor den Sanierungsmaßnahmen zu reinigen! Wenn nötig müssen Maßnahmen ergriffen werden um die richtigen Wassertemperaturen im System sicherzustellen. Dabei gilt: Die Kaltwassertemperatur muss
Thermische Desinfektion
Die thermische Desinfektion soll das gesamte System einschließlich aller Entnahmearmaturen erfassen. Bei einer Temperatur von>70 °C werden Legionellen in kurzer Zeit abgetötet. Trinkwassererwärmer sind auf eine Temperatur von>70 °C aufzuheizen. Jede Entnahmestelle ist bei geöffnetem Auslass mindestens drei Minuten mit mindestens 70 °C zu beaufschlagen – Temperatur und Zeitdauer sind unbedingt einzuhalten! (In vielen Fällen ist dies jedoch aufgrund der technischen Ausrüstung nicht möglich.) Die Entnahmestellen sind der Reihe nach hintereinander zu beaufschlagen. Zu beachten ist: Bei Altanlagen mit verzinktem Werkstoff muss mit Korrosionsschäden gerechnet werden!
Achtung: Die thermische Desinfektion führt nicht immer zur dauerhaften Verhinderung des Bakterienwachstums; sie ist nur eine kurzzeitig wirksame Maßnahme zur Verringerung der Keimzahl. Wird die Biomasse der abgetöteten Mikroorganismen nicht entfernt, so bildet sie den Nährstoff für eine nachfolgende Vermehrung von Bakterien. Zudem: Sofern keine geeignete Wasseraufbereitung vorgeschaltet wird, führt die Erhöhung der Temperatur in den Warmwasserleitungen zu einer verstärkten Kalkablagerung in der Verrohrung – und begünstigt damit wiederum das Einnisten von Legionellen.
Chemische Desinfektion
Eine kontinuierliche Zugabe von chemischen Desinfektionsmitteln muss im Einklang mit der gültigen Trinkwasserverordnung erfolgen. Nach derzeitigem Kenntnisstand werden Legionellen dadurch nicht ausreichend beseitigt. Eine diskontinuierliche Zugabe in hoher Konzentration (z.B. mindestens 10 mg/l freies Chlor an der Entnahmestelle) ist deshalb erforderlich. Das so gechlorte Wasser muss speziell entsorgt werden. Die Werkstoffverträglichkeit des Desinfektionsmittels muss der Betriebsvorschrift der Hersteller entsprechen (z.B. Wasserstoffperoxid für Edelstahl usw.). Die Maßnahme ist nach DVGWArbeitsblatt W 291 durchzuführen.
Vermeidung von Inkrustationen und Ablagerungen
Um unabhängig von der gelieferten Trinkwasserqualität die Biofilmbildung einzuschränken, muss nach VDI 6023 bzw. Stand der Technik folgendes beachtet werden:
- Vermeidung einer Überdimensionierung
- Verwendung von Installationswerkstoffen, von denen möglichst geringe verwertbare Nährsubstrate abgegeben werden
- Beachtung der Stagnationsproblematik
- Vermeidung von Temperaturbereichen, bei denen Bakterienwachstum, insbesondere das von Krankheitserregern, gefördert wird
- Vermeidung der Bildung von Schlamm, Kalkablagerungen und/oder Inkrustationen
- Regelmäßige Wartung und Instandhaltung durch fachlich geschultes Personal.
Der Kalk- und Korrosionsschutz ist somit ein wesentlicher Bestandteil des effizienten Hygiene-Managements. Dass Inkrustationen die Rohrinnenoberflächen vergrößern und somit den Keimen Wachstumsraum schaffen und sogar vor Desinfektionsmaßnahmen schützen – diese Tatsache wird in der Praxis sehr oft noch unterbewertet. Man muss immer wieder daran erinnern: Das Vermeiden von Schlamm, Ablagerungen und Inkrustationen im Warmwassersystem ist aus hygienischen Gründen eine absolute Notwendigkeit.
Lässt sich in alten, weitverzweigten Trinkwassersystemen auch nach mehrfachen Desinfektionen ein Wachstum der Mikroorganismen nicht eindämmen, muss nach § 5 Abs. 4 TrinkwV die Vorhaltung einer Desinfektionskapazität von freiem Chlor oder Chlordioxid vorgenommen werden. Vor allem das Chlordioxidverfahren eignet sich für die meisten Trinkwässer gut, da es hier zu keinen pH–Wert-Abhängigkeiten kommen kann (z.B. Reaxan-Anlagen). Die Anlagentechnik und der Betrieb müssen entsprechend den Vorgaben der so genannten UBA-Liste erfolgen.
Fazit
Wichtig ist ein ganzheitlicher Ansatz: Hygienische Sicherheit in der Hausinstallation ist nur dann gegeben, wenn das Zusammenspiel aller Komponenten korrekt geplant und ausgeführt wurde. Durch die TrinkwV wird der Betreiber einer öffentlichen Hausinstallation nicht nur mit den (eher sanften) Mitteln des Ordnungsrechts, sondern auch mit denen des (sehr viel härteren) Strafrechts in seine Verantwortung gezwungen. Es ist deshalb unbedingt ratsam, alle Maßnahmen hieb- und stichfest zu dokumentieren: Eine Dokumentation aller durchgeführten HygieneInspektionen, Wartungsarbeiten und Kontrolluntersuchungen hilft, der Verantwortung gemäß TrinkwV gerecht zu werden (und vor allem auch, diese nachweisen zu können!). Eine Schulung gemäß VDI 6023 kann Betreibern, Planern und Ausführenden die Grundlagen für die richtige, ganzheitliche Vorgehensweise vermitteln.
Checkliste
Hygiene-Problematik
In den letzten Jahren ist deutlich geworden, dass in Trinkwasser-Installationen ein ernst zu nehmendes mikrobiologisches Problem lauern kann. Neue Erkenntnisse belegen, dass Bakterien aus dem Trinkwasser weitaus häufiger für Infektionen verantwortlich sind als bisher vermutet. Als Schwachstellen identifizieren Fachleute dabei vor allem:
eine nicht fachgerechte Auslegung der Rohrleitungsnetze
hygienische Mängel bei der Installation
hygienische Mängel bei der Inbetriebnahme
Fehler beim späteren Betrieb durch den Betreiber.
Präventionsmaßnahmen
Folgende Maßnahmen sind bei der Planung und Installation von Trinkwasser-Anlagen von besonderer Bedeutung:
Keinen Nährboden bieten durch die Auswahl geeigneter Werkstoffe
Stagnationszeiten vermeiden durch die bedarfsgerechte Dimensionierung der Rohre sowie die Berücksichtigung der realen Druckverluste und des Nutzerverhaltens
Richtig dämmen, um die Qualität des Trinkwassers durch Abkühlen oder Erwärmen nicht zu beeinträchtigen
Die von den Bakterien für das Wachstum bevorzugten Temperaturbereiche vermeiden.
Wasserwechsel ist wichtig
Eine Trinkwasser-Installation soll so ausgelegt werden, dass ein häufiger Wasserwechsel begünstigt wird. Folgende Maßnahmen begünstigen dies:
kurze Steigeleitungen und Stockwerksverteilungen
Dimensionierung nach DIN 1988-3 mit möglichst geringen Abmessungen.
Anordnung des Hauptverbrauchers an das Ende einer Stichleitung.
Entnahmestellen in sensiblen Bereichen möglichst mit Ringleitungen oder mit Reihenleitungen anschließen, dann wiederum mit dem Hauptverbraucher am Ende.
Einsatz von Einzelsicherungen, Verzicht auf Sammelsicherungen.
Risikofaktor Temperatur
Mikroorganismen benötigen für ihre Vermehrung im Trinkwasser bestimmte Temperaturen. Daher sollte die Temperatur im Kaltwasser 25 °C nicht über- und im Warmwasser 55 °C nicht unterschreiten. Als Indikator für die Wasserbeschaffenheit in der Trinkwasser-Installation dienen u. a. folgende Bakterien:
Pseudomonas aeruginosa: Dieses Bakterium ist einer der wichtigsten durch Trinkwasser übertragbaren Erreger – insbesondere von im Krankenhaus ausgelösten Infektionen. Seine optimale Wachstumstemperatur liegt zwischen 25 und 30 °C.
Legionella pneumophila: Dieses Bakterium findet gute Bedingungen für eine Vermehrung vor allem im Temperaturbereich zwischen 25 und 45 °C.
„Die Trinkwasserverordnung fordert, die Qualität des Lebensmittels Trinkwasser bis zur Zapfstelle zu garantieren. Ansonsten drohen harte Sanktionen bis zur Anwendung des Strafrechts“.Thomas Gunkel, Leiter bei der BWT Wassertechnik in SchriesheimAutor
Dipl.-Ing. Thomas Gunkel ist Vertriebingenieur bei der BWT Wassertechnik in 69198 Schriesheim, Tel. (0 62 03) 73-0, Telefax (0 62 03) 73-1 02, http://www.bwt.de